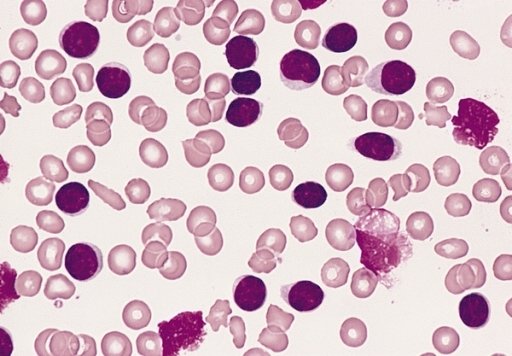

Overview
Chronic Lymphocytic Leukemia (CLL) is a type of blood cancer characterized by the gradual accumulation of abnormal lymphocytes, a kind of white blood cell, in the blood, bone marrow, and lymphoid tissues. In Korea, advanced hematology and oncology centers provide early diagnosis, targeted therapies, and comprehensive care to improve survival and quality of life.
What is Chronic Lymphocytic Leukemia?
CLL is a slow-growing leukemia that primarily affects adults, often over the age of 50. It is characterized by abnormal proliferation of B-lymphocytes, which are dysfunctional and accumulate in the blood and lymphoid organs. Many patients may remain asymptomatic for years, while others develop complications such as infections or anemia.
Symptoms
- Fatigue and weakness
- Swollen lymph nodes in the neck, armpits, or groin
- Unexplained fever or night sweats
- Unintentional weight loss
- Frequent infections due to impaired immunity
- Easy bruising or bleeding
- Enlarged spleen or liver in advanced cases
Causes
- Exact cause is unknown
- Genetic mutations affecting B-lymphocytes
- Family history of CLL or other blood cancers
- Exposure to certain chemicals or radiation (rare)
- Age-related changes in immune system function
Risk Factors
- Age over 50 years
- Male gender (slightly higher risk than females)
- Family history of leukemia or lymphoma
- Genetic predispositions affecting lymphocyte regulation
- Exposure to carcinogens in occupational settings (rare)
Complications
- Increased susceptibility to infections
- Anemia or low platelet counts leading to fatigue or bleeding
- Autoimmune disorders affecting blood cells
- Progression to aggressive leukemia or lymphoma in rare cases
- Organ enlargement causing discomfort or functional impairment
Prevention
- No guaranteed prevention due to unclear etiology
- Regular medical check-ups for at-risk individuals
- Avoid unnecessary exposure to carcinogens or radiation
- Healthy lifestyle and monitoring for early warning signs
Treatment Options in Korea
Treatment depends on the stage, symptoms, and overall health of the patient:
- Watchful waiting:
- For asymptomatic patients with early-stage CLL
- Regular monitoring of blood counts and lymph node size
- Medications:
- Chemotherapy agents such as fludarabine, cyclophosphamide
- Targeted therapies (e.g., BTK inhibitors like ibrutinib)
- Monoclonal antibodies (e.g., rituximab)
- Advanced interventions:
- Stem cell transplantation in select patients with aggressive or resistant disease
- Supportive care including infection prevention and blood transfusions
- Specialized hospitals in Korea:
- Samsung Medical Center Hematology and Oncology
- Seoul National University Hospital, Asan Medical Center, Severance Hospital
- Multidisciplinary teams including hematologists, oncologists, and supportive care specialists
- Follow-up care:
- Regular blood tests and imaging to monitor disease progression
- Management of treatment side effects
- Vaccinations and infection prevention strategies